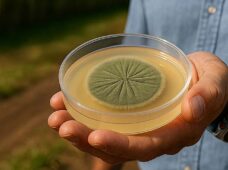
Falta de refrigeração compromete eficiência de bioinsumos no campo, alerta executivo do setor

Refrigeração
O uso de bioinsumos no Brasil tem mostrado um crescimento significativo nas últimas décadas, especialmente na safra 2024/2025. O uso de soluções biológicas no campo cresceu 13% em comparação à
A Mayekawa fornece equipamentos que auxiliam no armazenamento e na estocagem e transferência de amônia, como o BOG (Boil-off-Gas), equipamento que mantém a amônia armazenada em baixas temperaturas no sistema.
Marcos Fagundes, da Mayekawa do Brasil O retrofit industrial é o processo de atualização das máquinas, substituindo ou modernizando peças e equipamentos por modelos com versões mais recentes. O método implementa correções
Por mais que as instalações de Refrigeração Industrial obedeçam ao mesmo princípio há mais de 150 anos, alguns pontos nesta competência evoluíram. Quer sejam por questões econômicas ou sustentáveis –
Por mais que as instalações de Refrigeração Industrial obedeçam ao mesmo princípio há mais de 150 anos, alguns pontos nesta competência evoluíram. Quer sejam por questões econômicas ou sustentáveis –
Em um sistema de refrigeração o fluido refrigerante é responsável pela troca de calor entre os ambientes externo e interno. Com a evolução da tecnologia e a crescente preocupação com
Com tecnologia microcanal e 10 metros de comprimento, chiller com condensação a ar, desenvolvido pela Mayekawa do Brasil, foi utilizado para compor o sistema de climatização instalado em um prédio
Quando um sistema de refrigeração industrial que funciona com o fluido refrigerante amônia, contamina-se com umidade, nem sempre as consequências são verificadas de imediato, é praticamente um inimigo oculto que
A Mecalor está investindo na ampliação da área industrial com o objetivo de triplicar a fabricação de chillers e outras máquinas até novembro deste ano. Com isso, a empresa planeja